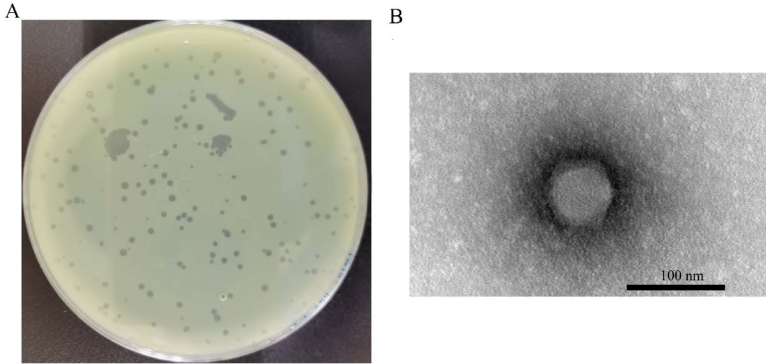

-
生物通官微
陪你抓住生命科技
跳动的脉搏
裂解性噬菌体Pa_WF01的特性及其对耐碳青霉烯类铜绿假单胞菌感染的治疗效果研究
【字体: 大 中 小 】 时间:2025年08月02日 来源:BMC Microbiology 4.2
编辑推荐:
本研究针对耐碳青霉烯类铜绿假单胞菌(CRPA)这一全球公共卫生威胁,从医院污水中分离鉴定出特异性裂解噬菌体Pa_WF01。研究人员通过全基因组测序、电镜观察和动物实验证实,该噬菌体具有短潜伏期(10分钟)、高裂解效率(每个细胞释放154个噬菌体)和广谱pH(4-12)/温度(4-50°C)稳定性,能显著提高CRPA感染小鼠存活率(60%),降低器官细菌载量和炎症因子(TNF-α/IL-6)水平。该研究为临床CRPA感染提供了新型治疗策略。
在全球抗生素耐药危机日益严峻的背景下,耐碳青霉烯类铜绿假单胞菌(CRPA)因其多重耐药特性被世界卫生组织列为重点防控病原体。这类"超级细菌"通过产β-内酰胺酶、外膜蛋白突变和主动外排泵过表达等机制,对包括碳青霉烯类在内的最后防线抗生素产生耐药,导致 ventilator-associated pneumonia(呼吸机相关肺炎)、sepsis(败血症)等重症感染治疗失败率显著升高。面对传统抗生素研发滞后的困境,科学家们将目光投向了自然界中细菌的"天敌"——噬菌体。
山东第二医科大学的研究团队从医院污水这一"天然噬菌体库"中,分离获得一株对临床CRPA菌株具有特异裂解活性的噬菌体Pa_WF01。通过系统的生物学特性研究和基因组分析,结合动物实验验证,证实该噬菌体不仅能有效清除CRPA感染,还能减轻宿主炎症反应,相关成果发表在《BMC Microbiology》上。
研究采用的主要技术方法包括:从医院污水样本中分离纯化噬菌体;通过透射电镜(TEM)观察噬菌体形态特征;测定最佳感染复数(MOI)、一步生长曲线等生物学参数;全基因组测序和生物信息学分析;建立免疫抑制小鼠CRPA感染模型评估治疗效果;ELISA检测炎症因子水平;组织病理学分析器官损伤程度。
研究结果部分显示:
噬菌体分离与特性表征:Pa_WF01在双层琼脂平板上形成直径约2mm的清晰噬菌斑,电镜显示其具有80nm的六边形头部和短尾结构,属于Schitoviridae科Litunavirus属。宿主范围试验证实其仅特异性裂解CRPA菌株。
生理学特性:该噬菌体展现出惊人的感染效率,在MOI低至0.0001时仍能有效增殖。一步生长曲线显示其潜伏期仅10分钟,每个感染细胞可释放154个噬菌体颗粒,远高于同类噬菌体。在pH4-12和4-50°C范围内保持稳定活性,但对氯仿敏感。

基因组特征:73,369bp的双链DNA基因组,GC含量54.78%,预测94个ORF。系统发育分析证实其与Pseudomonas phage PAP02亲缘关系最近(97.04%相似性)。未检测到tRNA、毒力基因和抗生素耐药基因,安全性良好。
体内治疗效果:在免疫抑制小鼠模型中,噬菌体治疗组存活率达60%,显著高于亚胺培南治疗组(37%)。治疗72小时后,肺、肝、脾中的细菌载量降低2-3个数量级,血清TNF-α和IL-6水平分别下降68%和54%,器官病理损伤明显减轻。

协同杀菌机制:血清杀菌实验发现,Pa_WF01能增强感染血清的补体杀菌活性,这种"噬菌体-免疫系统协同作用"为理解其治疗机制提供了新视角。
这项研究的重要意义在于:首次系统表征了Litunavirus属噬菌体对CRPA的裂解特性,其短潜伏期、高裂解效率的特性特别适合临床急症治疗;全基因组分析证实其不含潜在风险基因,安全性可靠;动物实验证实其治疗效果优于传统抗生素,且能调节宿主免疫反应。这些发现为开发CRPA特异性噬菌体鸡尾酒疗法奠定了理论基础,也为应对"后抗生素时代"的耐药菌威胁提供了新思路。未来研究可进一步探索噬菌体与抗生素的协同作用,以及规模化生产等转化医学问题。
生物通微信公众号
知名企业招聘